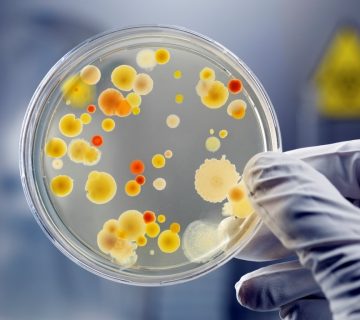

از سال ۲۰۲۲، ایمپلنتهای اندوستئال تیتانیوم تقریباً ۹۳ درصد از بازار ایمپلنتهای دندانی را تشکیل دادهاند. ایمپلنتهای تیتانیومی به دلیل استحکام، سازگاری زیستی و قیمت مقرونبهصرفه، بهعنوان بهترین ایمپلنتهای دندانی در نظر گرفته میشوند.
برخی از بهترین برندهای ایمپلنت دندان که بیشترین سهم بازار را در این صنعت دارند، ایمپلنتهای سوئیسی، آمریکایی و بعد از آن ایمپلنتهای کرهای هستند. این برندهای ایمپلنت، در بین دندانپزشکان و جراحان نیز محبوبترین و شناختهشدهترین نوع ایمپلنت دندانی هستند. این برندها عبارتاند از ایمپلنت استرومن سوئیس، ایمپلنت سوئیسی نوبل بیوکر، ایمپلنت آمریکایی دنتسپلای سیرونا و ایمپلنت زیمر آمریکا. این شرکتها دارای سابقه طولانی در تولید ایمپلنت بوده و بسیاری از آنها، بیش از ۲۵ سال تجربه ساخت ایمپلنت، دارند.
به گفته دکتر آرش گلستانه متخصص کاشت دندان در اصفهان:
یک مسأله را خدمت بیماران عزیز باید بگوییم که در کل، انتخاب پزشک عملکننده بسیار مهمتر از انتخاب برند ایمپلنت است؛ چهبسا بهترین و گرانترین برند ایمپلنت اگر خوب کار نشود؛ ممکن است که به نتیجهی دلخواه نرسیم و ایمپلنت با استخوان جوش نخورد و از دهان خارج شود.
۶ عدد از بهترین برندهای ایمپلنت دندان
شرکتهایی که در زیر موردبحث قرار میگیرند، از بهترین شرکتهای سازنده ایمپلنت دندان در سطح دنیا هستند. هر شرکتی مجموعهای از مزایای منحصربهفرد خود را ارائه میدهد. در زیر با فهرستی ۷تایی از بهترین برندهای ایمپلنت دندان آشنا میشوید:
ایمپلنت استرومن سوئیس
تأسیس: ۱۹۵۴
Straumann ، اولین ایمپلنت یکمرحلهای تیتانیومی جهان را در سال ۱۹۷۴، معرفی کرد. از آن زمان، نام تجاری شرکت استرومن و سایر محصولات پزشکی این شرکت، به تولید مواد باکیفیت شناخته شدهاند که هم قابلیت اطمینان و هم ایمنی را برای جراح و بیمار، فراهم میکند.
شرکت استرومن، به دلیل آزمایش محصولات بالینی و انجام تحقیقات گسترده و مداوم در زمینه ایمپلنت، مشهور است. این شرکت برای آزمایشات خود، با بسیاری از مؤسسات تحقیقاتی، دانشگاهها و کلینیکهای معروف و شناخته شده بینالمللی، همکاری میکند.
سایر اطلاعات درباره ایمپلنت استرومن
ایمپلنت استرومن، خط گستردهای از محصولات را برای بازسازی بافت دندان، ایجاد کرده است و علاوه بر ساخت ایمپلنتهای دندانی، ابزار و قطعات خود را نیز برای استفاده در سیستمهای ایمپلنت، طراحی و تولید میکند.

ایمپلنت سوئیسی نوبل بیوکر
تأسیس: ۱۹۸۱
تمرکز این شرکت بر روی ساخت ایمپلنتهای دندانی و محصولات مرتبط با ایمپلنت مانند اباتمنتها و ایمپلنتهای ترمیمی از جمله تاج و بریج است. این شرکت، در مجموع بر اساس بیش از ۶۵ سال تحقیق و نوآوری مستمر ساخته شده و همگی از تحقیقات برونمارک و کشف پیشگامانه در ادغام استخوانی در اوایل دهه ۱۹۵۰، سرچشمه میگیرد.
سایر اطلاعات درباره نوبل بیوکر
شرکت تجاری ایمپلنت دندان Noble Biocare ، از طریق آموزش و توسعه حرفهای، از مشتریان خود پشتیبانی میکند و خدمات خوبی به مشتریان خود ارائه میدهد. اخیراً، نوبل بیوکر تلاشهای خود را در سیستمهای جراحی هدایت شده، برای کمک به دندانپزشکان برای بهبود نتایج جراحی، گسترش داده است.
ایمپلنت آمریکایی دنتسپلای سیرونا
شرکت دنتسپلای سیرونا، در سال ۱۸۹۹، در شهر نیویورک آمریکا تأسیس شد. دنتسپلای سیرونا، خط ایمپلنت خود را در اوایل دهه ۱۹۸۰ توسعه داده و در سال ۱۹۸۵ به تولید انبوه رساند.
بسیاری از ابداعات ایمپلنت دنتسپلای، از گوشدادن به نظرات مشتریان خود ناشی میشود. این شرکت با یافتن اینکه چه مواردی مناسب و کدام یک از قسمتهای ایمپلنت دندان نامناسب است، تلاش میکند راهحلهایی برای افزایش راحتی بیمار، کاهش زمان درمان و روشهای سادهتر، ایجاد کند.
محصولات ایمپلنت دنتسپلای، بر پایه تحقیقات گسترده شرکت Astra Tech Dental، ساخته شده است. همه محصولات، قبل از اینکه به بازار معرفی شوند چندین سال، موردمطالعه قرار گرفته، توسعه داده شده و تأیید میشوند. تحقیق و توسعه شرکت دنتسپلای، بر روی تمام جنبههای درمان ایمپلنت، از جمله سادهسازی روش درمان و مطالعات گسترده بالینی، تمرکز دارد.
سایر اطلاعات درباره دنتسپلای سیرونا
شرکت ایمپلنت دنتسپلای سیرونا، محصولات خود را برای پاسخگویی به نیازهای دندانپزشکی ایمپلنت، در سال ۲۰۲۲ و پس از آن گسترش داده است. شرکت دنتسپلای سیرونا، با ارائه یکی از جامعترین برنامههای گارانتی، یکی از شرکتهای قدرتمند در زمینه پشتیبانی از بیماران دریافتکننده ایمپلنت، است.
ایمپلنت آمریکایی زیمر
تأسیس: ۱۹۲۷
،Zimmer Dental در سال ۱۹۲۷ و در کشور آمریکا، تأسیس شد. درآمد دندانپزشکی این شرکت در سال ۲۰۱۵، ۳۳۶ میلیون دلار بود. آنها با Biomet 3i ادغام شده و به Zimmer Biomet Dental تبدیل شدند. شرکت زیمر، بیش از دو دهه است که ایمپلنتهای دندانی و همچنین مواد احیاکننده از جمله جایگزینهای پیوند استخوان، غشاهای کلاژن و ابزار دندانپزشکی، تولید میکند.

سایر اطلاعات درباره ایمپلنت زیمر
Zimmer Biomet، مسئول طراحی، توسعه و تولید و بازاریابی محصولات ارتوپدی است. اینها شامل مفاصل مصنوعی و محصولات پروتز دندان است. Zimmer Biomet، در بیش از ۲۵ کشور در سراسر جهان، فعالیت میکند و محصولات آن در بیش از ۱۰۰ کشور در جهان، به فروش میرسد.
ایمپلنت آمریکایی بایوهورایزن
تأسیس: ۱۹۹۴
این شرکت بر اساس آزمایشات تحقیقاتی انجام شده در دانشگاه آلاباما در بیرمنگام در سال ۱۹۹۴، توسط تعدادی از متخصصهای معروف ایمپلنت، تأسیس شد.
بایوهورایزن، به استفاده از تحقیقات علمی جامع، برای تولید محصولات مبتکرانه و باکیفیت، از جمله ایمپلنت و مواد بازسازیکننده استخوان فک، ادامه میدهد.
سایر اطلاعات درباره ایمپلنت بایوهورایزن
آزمایشهای تحقیقاتی در دنیای واقعی، برای ارزیابی اینکه چگونه ایمپلنتهای بایوهورایزن میتوانند برای بیماران مفید باشند، انجام میشود. این آزمایشها یک پیگیری طولانیمدت ۱۰ساله هستند. مطالعات علمی نشان داده است که ایمپلنتهای بایوهورایزن، نرخ بقای بسیار بالایی دارند؛ به طور متوسط ۹۹.۲٪، با حداقل ازدستدادن استخوان.

ایمپلنت آمریکایی بیکن
تأسیس: ۱۹۸۵
ایمپلنت بیکن، یک برند ایمپلنت آمریکایی است که به دلیل ایجاد ایمپلنتهای تیتانیومی کوتاه ۸ میلیمتری، شناخته شده است. ایمپلنت بیکن، قراردادن ایمپلنتهای دندانی را در مناطقی که ارتفاع استخوان محدود بوده و پیوند استخوان گسترده، نشدنی است، ممکن میسازد.
تحقیقات این برند بر اساس درخواست ارتش ایالات متحده که بودجه توسعه یک ایمپلنت تک دندانی مستقل را تأمین کرده، شکلگرفته است. علاوه بر این، شرکت بیکن روی توسعه مواد لازم برای پیوند استخوان مصنوعی، کار میکند.
سایر اطلاعات درباره ایمپلنت بیکن
ایمپلنتهای بیکن، برای همه افراد طراحی نشدهاند. آنها بازاری ویژه دارند و به بیماران این امکان را میدهند تا ترمیمهای مبتنی بر ایمپلنت را با محصولاتی که توسط اکثر تولیدکنندگان بزرگتر ارائه نمیشود، تجربه کنند.
نتیجهگیری با عنوان بهترین برند ایمپلنت دندان
پیشرفتهای فناوری، با تمرکز برندهای ایمپلنت روی راهحلهای نوآورانه، برای عوامل مهمی مانند ادغام استخوانی، در حال شکلدهی به دندانپزشکی ایمپلنت است. برخی از برندهای ایمپلنت دندان نیز در حال بررسی استفاده از فناوریهای چاپ سهبعدی، برای ایجاد ایمپلنتهای سفارشی هستند که رویکرد شخصیتر برای ترمیم دندان را ارائه میدهد. همانطور که تکنولوژی به پیشرفت خود ادامه میدهد، میتوانیم انتظار داشته باشیم که برندهای ایمپلنت دندان راهحلهای پیشگامانهتری را معرفی کنند که کارایی و ایمنی روشهای کاشت دندان را بهبود میبخشد.
در بالا به تعدادی از بهترین ایمپلنتهای دندان در دنیا، اشاره شد. باتوجهبه موارد بالا، ایمپلنتهای سوئیسی در درجه اول و بعد از آن ایمپلنتهای آمریکایی، بهترین ایمپلنتهای دندانی در دنیا و تا به امروز، هستند.
البته همه این ها به تبحر و تجربه و تخصص دندانپزشک نیز بستگی دارد. (لیستی از بهترین متخصص ایمپلنت تهران، کرج، اصفهان و ….)
به گفته دکتر آرش گلستانه متخصص ایمپلنت و کاشت دندان:
یک مسأله را خدمت بیماران عزیز باید بگوییم که در کل، انتخاب پزشک عملکننده بسیار مهمتر از انتخاب برند ایمپلنت است؛ چهبسا بهترین و گرانترین برند ایمپلنت اگر خوب کار نشود؛ ممکن است که به نتیجهی دلخواه نرسیم و ایمپلنت با استخوان جوش نخورد و از دهان خارج شود.